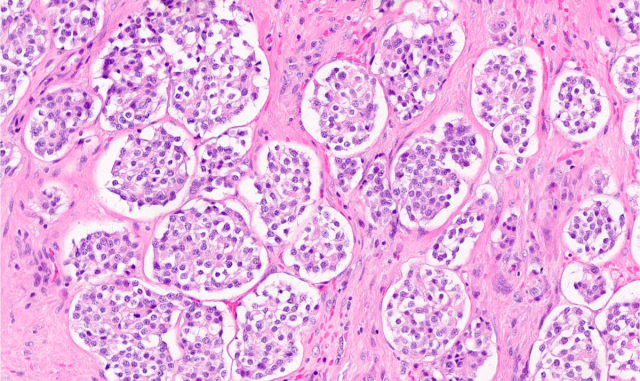

Cancer Predisposition Syndrome
DICER1 syndrome is a genetic disorder associated with an increased risk for developing tumors in the lungs, kidneys, ovaries, thyroid ...

Cancer Predisposition Syndrome
PTEN Hamartoma Tumor Syndrome (PHTS) comprises a group of clinical disorders characterized by genetic alterations in the PTEN gene. Such ...

Cancer
Differentiated thyroid cancer (DTC) includes papillary thyroid cancer (PTC) and follicular thyroid cancer (FTC). PTC is the most common form ...
Cancer
Medullary thyroid cancer (MTC) is a rare form of cancer that accounts for less than 2% of all thyroid cancers ...

Thyroid Hormone Deficiency
Hypothyroidism is a common endocrine disorder in which your child’s thyroid gland does not produce enough thyroid hormone. A ...

Autoimmune Disorder
Graves’ disease occurs when your child’s immune system develops antibodies that attach to the thyroid cells, causing them to ...
